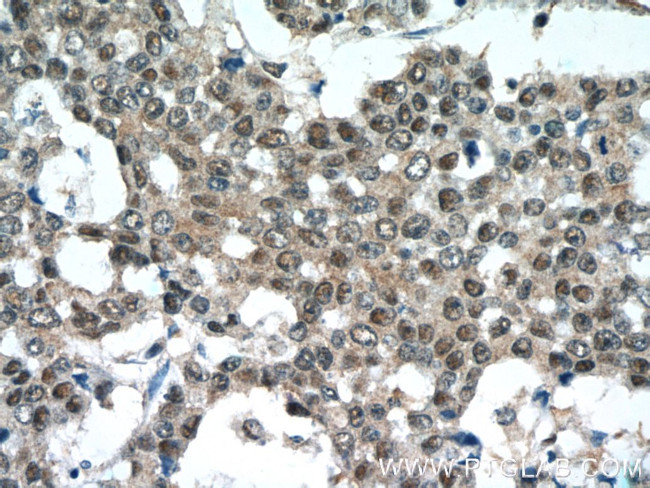
NEDD8 Antibody in Immunohistochemistry (Paraffin) (IHC (P))
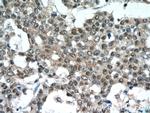
NEDD8 Antibody in Immunohistochemistry (Paraffin) (IHC (P))

Search
Proteintech
NEDD8 Polyclonal Antibody
{{$productOrderCtrl.translations['antibody.pdp.commerceCard.promotion.promotions']}}
{{$productOrderCtrl.translations['antibody.pdp.commerceCard.promotion.viewpromo']}}
{{$productOrderCtrl.translations['antibody.pdp.commerceCard.promotion.promocode']}}: {{promo.promoCode}} {{promo.promoTitle}} {{promo.promoDescription}}. {{$productOrderCtrl.translations['antibody.pdp.commerceCard.promotion.learnmore']}}
产品信息
16777-1-AP
种属反应
宿主/亚型
分类
类型
抗原
偶联物
形式
浓度
规格
纯化类型
保存液
内含物
保存条件
运输条件
产品详细信息
Immunogen sequence: MLIKVKTLT GKEIEIDIEP TDKVERIKER VEEKEGIPPQ QQRLIYSGKQ MNDEKTAADY KILGGSVLHL VLALRGGGGL RQ (1-81 aa encoded by BC104664)
靶标信息
NEDD8 is a ubiquitin-like protein which plays an important role in cell cycle control and embryogenesis. Covalent attachment to its substrates requires prior activation by the E1 complex UBE1C-APPBP1 and linkage to the E2 enzyme UBE2M. Attachment of NEDD8 to cullins activates their associated E3 ubiquitin ligase activity, and thus promotes polyubiquitination and proteasomal degradation of cyclins and other regulatory proteins.
仅用于科研。不用于诊断过程。未经明确授权不得转售。
生物信息学
蛋白别名: NEDD-8; NEDD8; Neddylin; Neural precursor cell expressed developmentally down-regulated protein 8; neural precursor cell expressed, developmentally down-regulated 8; neural precursor cell expressed, developmentally down-regulated gene 8; Ubiquitin-like protein NEDD8
基因别名: NEDD-8; NEDD8; Rub1
UniProt ID: (Human) Q15843, (Rat) Q71UE8, (Mouse) P29595
Entrez Gene ID: (Human) 4738, (Rat) 25490, (Mouse) 18002